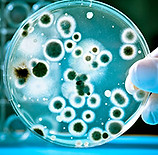

FDA | OSHA | SQF | BCAS | NFPA 1989 | ISPE | IICRC

Asbestos, Lead, & Mold Testing for Restoration
New York State Licensed Inspector
Compressed Air Testing: ISO-8573
Improper maintenance, inadequate or damaged filters, insufficient purging after changes to existing piping can all result in rust, dirt, and metal shavings on your final product.
PARTICLES


The length and condition of the distribution line, piping, drops, dead ends, condensate traps, and polymer tubing can collect liquid water. This creates a breeding ground for additional contamination.
WATER
According to ISO 8573, both oil aerosol and oil vapor must be monitored to meet purity classes 1 and 2. This is commonly called Total Oil. Even oil-free compressors can be contaminated with oil due to atmospheric air, inadequate filtration, or cleaning solvents.
TOTAL OIL


Excess water and oil can create an optimal breeding ground for additional contamination. Bacteria, yeast, and mold are all particularly dangerous to end products and can result in recalls and loss of production time. ISO 8573-7 states that compressed air must be monitored for microbial growth.
MICROORGANISMS


Licensed NYS Mold, Lead & Asbestos Assessor
Serving Communities: Suffolk, Queens, Brooklyn, Bronx, Manhattan, Westchester.
Commack, Merrick, Hauppauge, Bayshore, Smithtown, Garden City, Syosset, Woodbury, Stony Brook, Babylon, Valley Stream, West Babylon, Jericho, Bronxville, Eastchester, Brentwood, Port Washington, Mamaroneck, Jamaica, Brookville, Lindenhurst, East Setauket, Farmingdale, Centereach, Lake Ronkonkoma, Bohemia, Eastport, Oceanside, Fort Salonga, Old Field, Hudson Valley, Moriches, Yonkers, Levittown, Oyster Bay, Astoria, Locust Valley, Long Beach, Setauket, Mount Sinai, Wading River, Shoreham, Baldwin, Woodmere, Whitestone, Maspeth, Hempstead, Plainview, South Hampton, Elmont, West Hampton, East Hampton, Bridgehampton, Freeport, Riverhead, Deer Park, Huntington, New Rochelle, Kings Park, Merrick, Massapequa, Long Beach, Glen Cove, Mineola, Sayville, Far Rockaway, Northport, East Northport, Greenlawn, Brookhaven, Montauk, Sagaponack, Cold Spring Harbor, Watermill, Manorville, Miller Place, Rocky Point, Port Jefferson, Patchogue, St. James, Amityville, Islip, West Islip, Bayport, Bellport, Manorville, Laurel, Mattituck, Southhold, Queens Village, Forrest Hills, Flatbush, Brighton Beach, Bayridge, Jackson Heights, Breezy Point, Bensonhurst, Scarsdale, Mt. Vernon, Dobbs Ferry, Larchmont, Rye, Port Chester, Central Islip, White Plains, Sands Point.